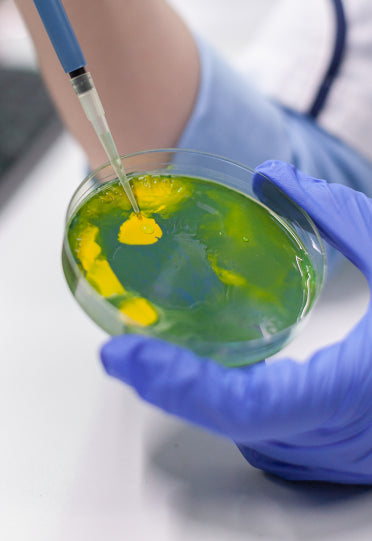
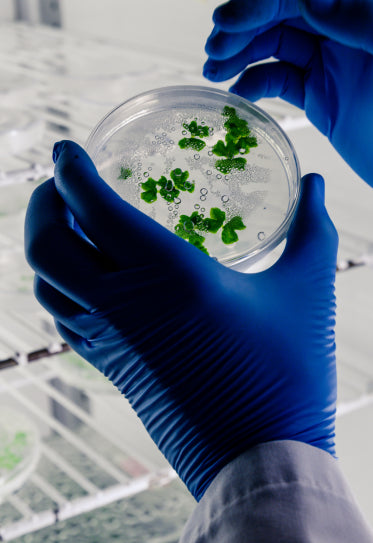

The Dose Of Naturals Difference
Welcome to Dose Of Naturals, your trusted source for high-quality essential oils and natural wellness products. Our journey began with a vision to create a company that would provide pure, ethically sourced essential oils that could transform lives. Today we are proud to be a part of this enormous industry offering an extensive range of premium essential oils and natural products.We are passionate about promoting health and well-being through the power of nature. At Dose Of Naturals, we believe in harnessing the incredible benefits of essential oils to support your physical, mental and emotional wellness. Our carefully curated collection of essential oils and related products is sourced from trusted farmers and suppliers worldwide. We prioritize quality and purity, ensuring that every item meets our rigorous standards. In addition to essential oils, we offer a range of complementary products such as carrier oils, hydrosols and Chakra Blends to enhance your wellness routine.
A Foundation Built On Sustainability And Ethics
At Dose of Naturals, sustainability and ethics are not just buzzwords; they are the guiding principles that shape our business. We respect and honour the delicate balance of nature. Our essential oils are derived from plants that are carefully and sustainably harvested. From the sourcing of our essential oils to the packaging of our products, we take deliberate steps to reduce waste, conserve resources and promote sustainable practices.
Join us on this journey towards a more sustainable and ethical future.
-

Ethical sourcing
-

Fair Trade
-

Social Responsibility
All Products Comes With A Promise Of Safety & Purity
Our in-house certified aromatherapists are dedicated to ongoing research and education.
You can email our aromatherapists directly.
-

Against Animal Cruelty
Our in-house certified aromatherapists are dedicated to ongoing research and education.
-

Friendly & Professional Service
Our in-house certified aromatherapists are dedicated to ongoing research and education.
-

Transparent, Natural Food System.
Our in-house certified aromatherapists are dedicated to ongoing research and education.
-

Regulatory or Marketing Status
Our in-house certified aromatherapists are dedicated to ongoing research and education.
-

Export Promotion Council For Chemicals
Our in-house certified aromatherapists are dedicated to ongoing research and education.
-

Quality Standard Movement
Our in-house certified aromatherapists are dedicated to ongoing research and education.
-

Manufacturer Complies With GMP
Our in-house certified aromatherapists are dedicated to ongoing research and education.
-

Against Animal Cruelty
Our in-house certified aromatherapists are dedicated to ongoing research and education.
-
More than 200+ essential oils in stock
Our in-house certified aromatherapists are dedicated to ongoing research and education.
Explore More
Our Global Sourcing Network

We take pride in our commitment to worldwide sourcing, which allows us to bring you the finest essential oils from every corner of the globe.
SOURCING COUNTRY
-

United States
-

India
-

Mexico
-

Europe
-

Indonesia
-

Egypt
-

Australia
-

Maracco
-

Brazil
-

Iran
-

Turkey
-

China

Crafted With Care: Ensuring Quality You Can Trust
We uphold rigorous standards and have established a comprehensive quality and testing process to ensure that every bottle of our essential oil meets the highest standards of purity and authenticity.Experience the difference of our exceptional essential oils and discover the power of nature in every drop.
-

Sourcing through vetted suppliers
-

Gas chromatography analysis
-

Organoleptic evaluation
-

Research and innovation